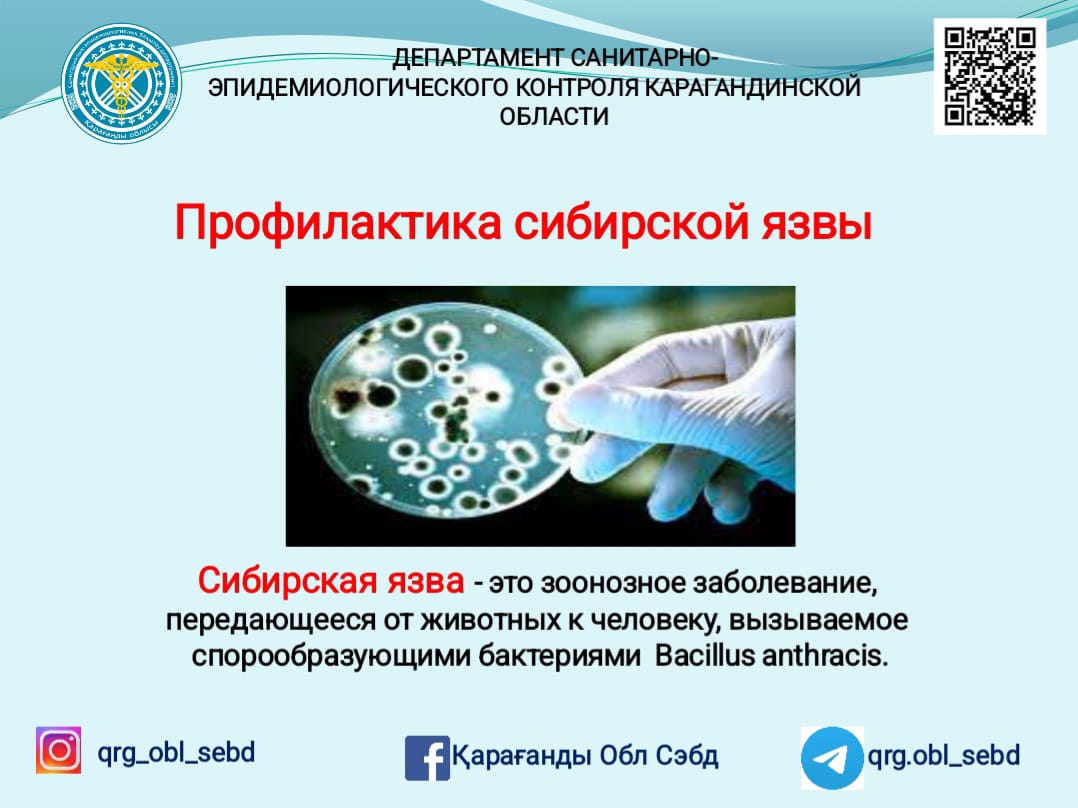
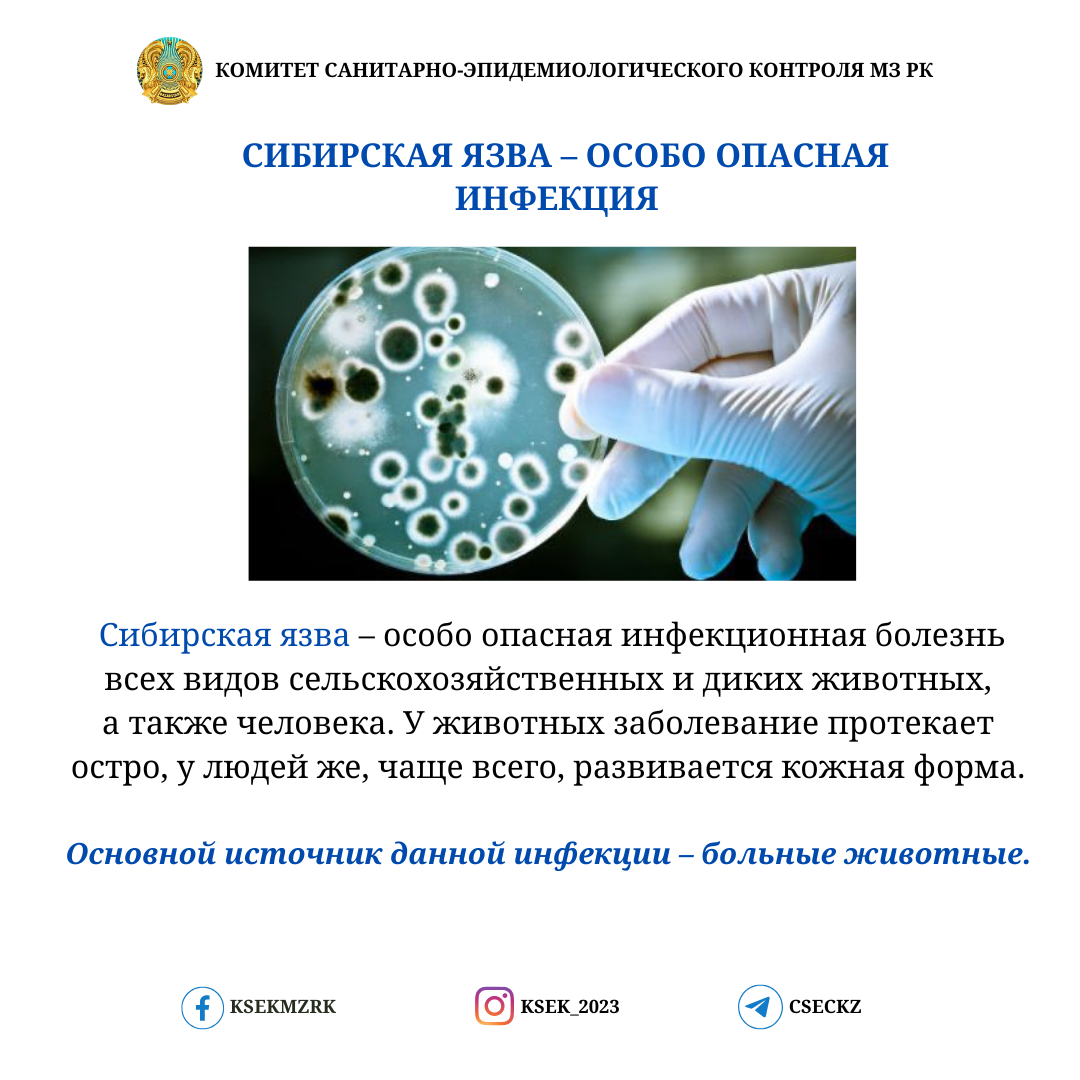
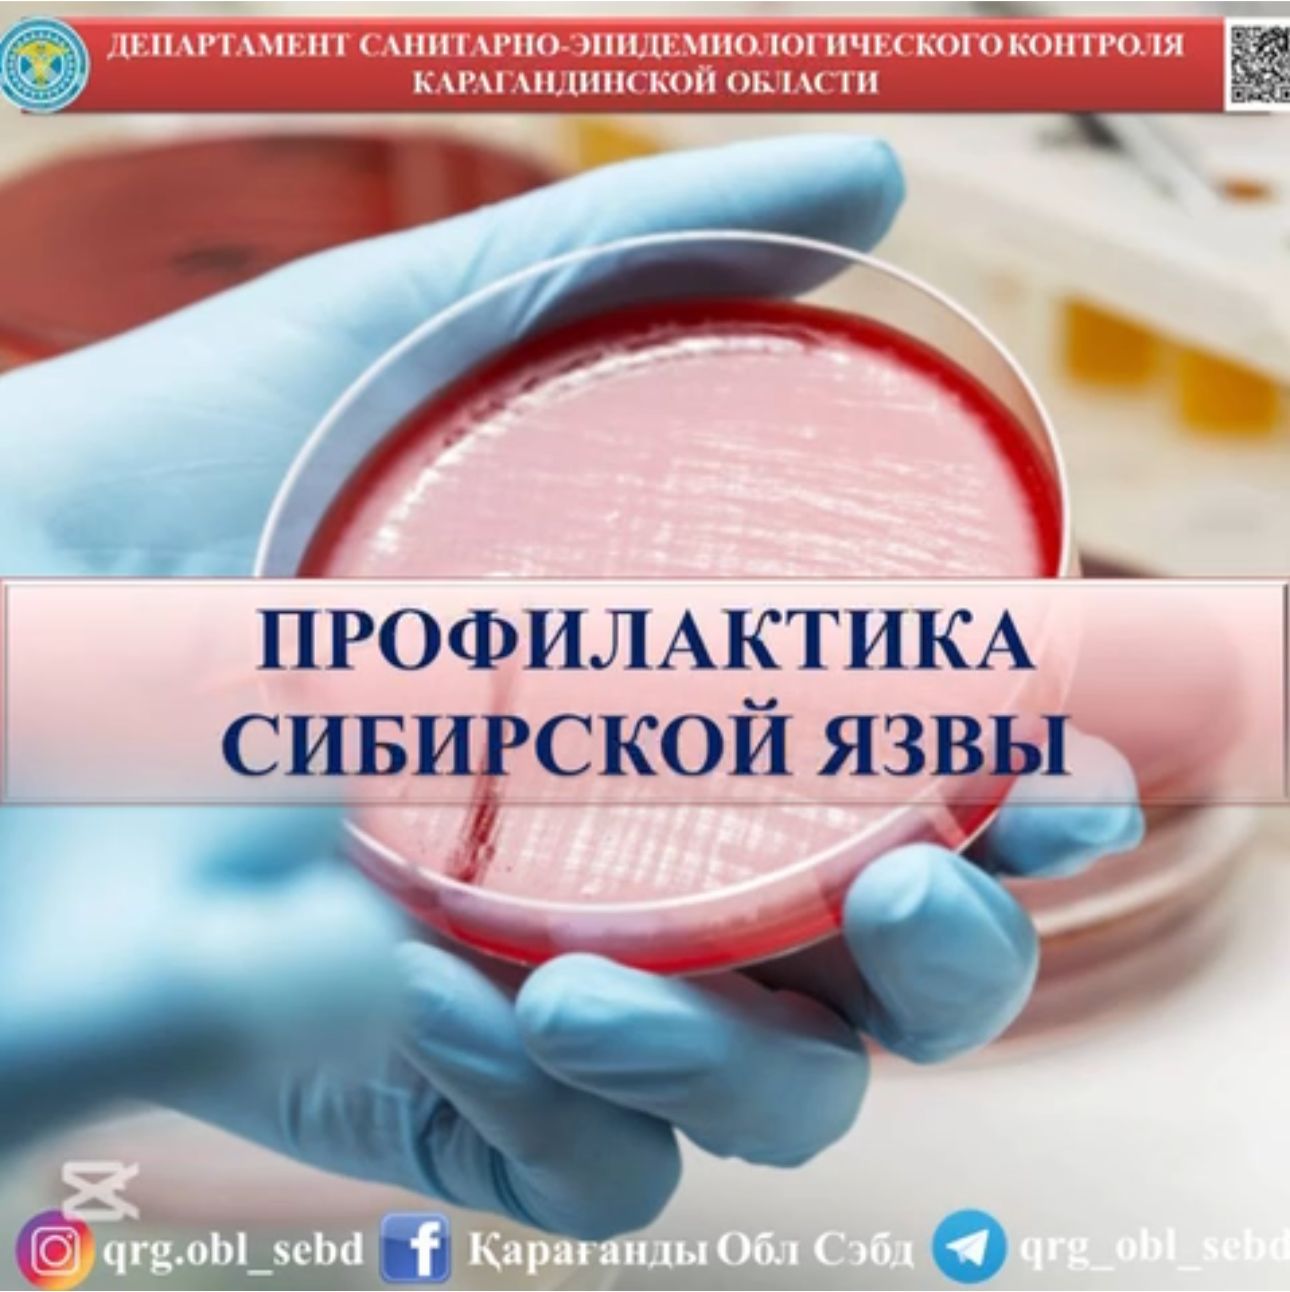

Приказ сибирская язва
Приказ сибирская язва 119 фото
Эйдосы аристотеля
Рабочая тетрадь журавлевой 5 класс
Песня ну ок хасан блэк раша
Нормативы бега на 200 метров
Русский язык 9 класс ладыженская 242
Станция ховрино метро ховрино автобус
Хорошо ждем в гости
Сош 20 воронеж
Нанесение лака на стену
Люстра с пультом управления не включается